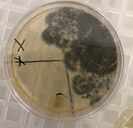

Pillen, Pulsschlag und Prothesen - Dechemax-Wettbewerb

Recht einfach bekämpfen wir heutzutage Krankheiten, die für die Menschen noch vor hundert Jahren den sicheren Tod bedeutet hätten. Ein paar Leibniz-Schüler haben sich von DECHEMAX in die Forschungslabore und in die Apotheken von gestern und heute entführen lassen, wo Chemiker, Biotechnologen und Pharmazeuten neue Medikamente entwickeln.

Nachfolgend werden fünf Schülerinnen und Schüler aus den Q1 Grund- und Leistungskursen interviewt.
Frau Winkelmann: "Wir haben euch nun längere Zeit in unserer Chemiesammlung experimentieren lassen. Zahlreiche Nachmittage und Freistunden habt ihr nun selbstständig und ohne Anweisungen von uns an euren Versuchen geforscht. Aber worum geht es dabei überhaupt? Berichtet doch einmal der restlichen Schule von euren Erfahrungen und Erlebnissen."
Sanela: „Ja, gerne. Vielleicht erzähle ich euch erst einmal von vorne. Anfang Oktober hat uns Frau Winkelmann auf den Wettbewerb aufmerksam gemacht. Hierbei handelt es sich um einen Teamwettbewerb, bei dem man in der ersten Runde jede Woche jeden Mittwoch eine naturwissenschaftliche Frage beantworten musste. Im Januar hatten wir dann 6 von 8 Fragen richtig beantwortet und uns somit für die 2. Runde qualifiziert.“
Frau W.: „Die 2. Runde scheint aber etwas umfangreicher zu sein. Außerdem – wie wir miterleben – handelt es sich hierbei um eine Experimentalrunde. Die zahlreichen Petrischalen und der Geruch nach Gemüsebrühe und Desinfektionsmittel, die wir beim Betreten der Sammlung wahrgenommen haben, machten uns doch sehr neugierig.
Erzählt mal, was untersucht ihr eigentlich?“

Anton: „Wir untersuchen Bakterienkulturen, dazu mussten wir zunächst Nährböden ansetzen, welcher aus Brühe, Agar-Agar und Zucker besteht. Danach haben wir den Unterschied zwischen desinfizierten, mit Seife und ungewaschenen Händen analysiert, indem wir einen Fingerabdruck genommen haben. Eine weitere Aufgabe war es den Bildschirm unserer Handys zu untersuchen, wobei erschreckende Ergebnisse zum Vorschein kamen. Aus reiner Neugierde haben wir dann noch zusätzlich den Bakterienstatus unserer Schule untersucht.“
Frau W.: „Interessant! Auf die Ergebnisse bin ich gespannt. Was hat euch denn dazu bewegt, so viel Zeit zu investieren?“
Florian: „Am meisten motiviert hat die Tatsache, dass wir u.a. auch den Laptop eines Lehrers untersuchen durften. Außerdem haben wir die Türklinken und die Kaffeemaschine der Physiker betrachtet. Entwarnung gab es bei der Kaffeemaschine. Am besorgniserregendsten war jedoch der Lehrerlaptop. Das Beste daran ist aber, dass wir den Lehrer sensibilisieren konnten, diesen endlich zu reinigen. Desinfektionsmittel konnten wir ihm geben.“

Frau Winkelmann lacht: „Stimmt! Was hat euch denn am besten bei diesem Wettbewerb gefallen?“
Jana: „Am schönsten war, dass wir alleine ohne Anweisungen frei experimentieren konnten. Man fühlte sich viel freier und nach und nach auch vertrauter mit den Durchführungen.“
Die anderen nicken.
Sanela: „Das Arbeiten im Team war sehr motivierend, wir konnten entspannter experimentieren und vertieften durch unsere Gespräche über die Versuche unser Wissen. Dadurch kamen uns immer mehr Ideen. Faszinierend finden wir aber auch die Chemiesammlung, weil es hier immer etwas Neues zu entdecken gab. Auch, weil dies eigentlich ein für Schüler nicht befugter Bereich ist.“
Frau W.: „Ja, da hattet ihr tatsächlich ein besonderes Privileg und wir in euch großes Vertrauen. Wie geht es nun weiter?“
Julius: „Wir hoffen, dass wir noch weiter kommen und zur Achema in Frankfurt eingeladen werden.“
Frau W.: „Das wünsche ich euch auch! Das wäre sicherlich noch eine besondere Erfahrung."
Frau W.: "Würdet ihr andere auch zur Teilnahme motivieren?“
Sanela: „Wenn man Spaß an Chemie hat und gerne experimentiert, dann sollte man sich nächstes Schuljahr mit seinen Freunden anmelden.“
Frau W.: „Übrigens gibt dies auch Punkte für unser MINT-EC-Zertifikat, was unsere Schüler/-innen zum Abitur erwerben können. Ich wünsche euch nun noch viel Erfolg und drücke euch beide Daumen, dass eure Anstrengungen belohnt werden.“